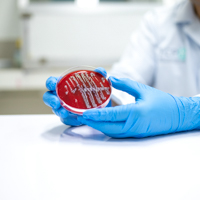
Improve Your Experiments with FlouroDish Cell Culture Dishes

Choosing the Right Culture Dish Coating


Choosing the Right Culture Dish Coating
A Practical Guide for Cell Culture Success
With various options available for treated or untreated cell culture surfaces, how do you choose the right one for your research? From synthetic polycationic coatings like poly-L-lysine to ECM proteins like fibronectin and vitronectin, each surface treatment offers unique benefits tailored to specific applications and experimental goals. The choice impacts more than just adhesion. It can influence cell viability, behavior, differentiation, and even affect experimental reproducibility.
In this final post of our series, we’ll summarize the five coatings available on WPI’s our FluoroDish™ glass-bottom culture dishes and help you match the right surface to your application.
Quick-Reference Comparison Table
| Coating | Type | Mechanism | Best For | Available On | Wall Color |
| Collagen | ECM protein (natural) | Integrin binding | Fibroblasts, hepatocytes, epithelial cells, neurons | 35 mm FluoroDish™, 23 mm glass bottom | Clear |
| Poly-D-Lysine | Synthetic (D-form) | Electrostatic interaction | Long-term neuronal and glial cultures | 35 mm FluoroDish™, 23 mm glass bottom | Clear |
| Poly-L-Lysine | Synthetic (L-form) | Electrostatic interaction | Short-term culture, fixed imaging, transfection assays | 35 mm FluoroDish™, 23 mm glass bottom | |
| Fibronectin | ECM protein (natural) | Integrin (RGD motif) | Endothelial, epithelial, stem cells; migration assays | 35mm FluoroDish™ with 23 mm glass bottom | |
| Vitronectin | ECM protein (natural) | Integrin (αVβ3, αVβ5) | iPSCs, ESCs; xeno-free, feeder-free defined systems | 35mm FluoroDish™ with 23 mm glass bottom |
Which Coating Should You Choose?
- For general cell culture with physiological relevance, choose Collagen. It supports natural adhesion and differentiation, especially for fibroblasts and tissue-specific models.
- For long-term neuronal or astrocyte cultures, choose Poly-D-Lysine (PDL). It resists enzymatic breakdown and supports stable, extended adhesion.
- For short-term adhesion, choose Poly-L-Lysine (PLL). It’s ideal for quick assays, fixed-cell imaging, or test runs.
- For directed differentiation, choose Fibronectin. It is great for mimicking ECM signaling and supporting tight junctions in epithelial/endothelial layers.
- For feeder-free pluripotent stem cell culture, choose Vitronectin, because it supports adhesion and self-renewal in xeno-free systems with defined media.
Why Use WPI’s FluoroDish™ for Coated Cultures?
No matter which coating you choose, your results are only as good as the surface it’s applied to. WPI’s FluoroDish™ glass-bottom dishes offer:
- Non-fluorescent, optical-grade clarity for high-resolution imaging
- Ultra-thin glass bottoms for fast, even heat transfer
- Optimal dish sizes and well formats for tailored applications
- Provide consistent and high-quality plates with coatings
- Coating options that save time and improve consistency
Whether you're capturing images of live neural networks or maintaining fragile iPSC colonies in defined media, FluoroDish™ offers a surface you, and your cells, can trust.
Missed a Post in the Series? Catch Up Here:
- How Surface Treatments Impact Cell Culture Growth (Overview)
- Collagen Coated Culture Dishes
- Poly-D-Lysine Coated Culture Dishes
- Poly-L-Lysine Coated Culture Dishes
- Fibronectin Coated Culture Dishes
- Vitronectin Coated Culture Dishes